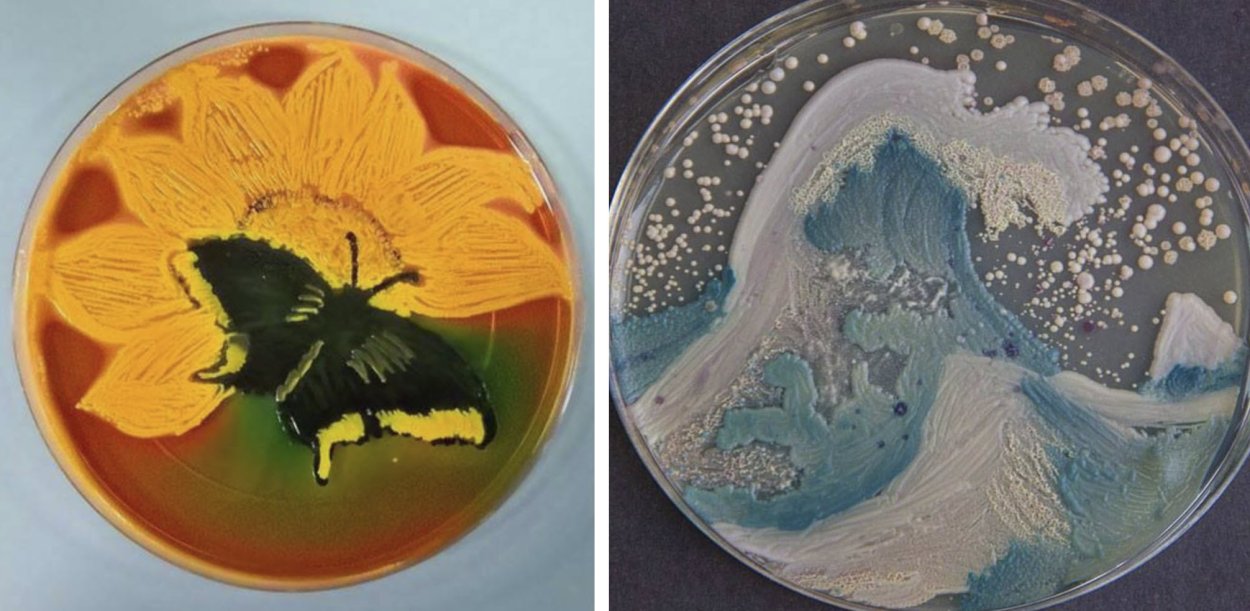
Раскидистое дерево
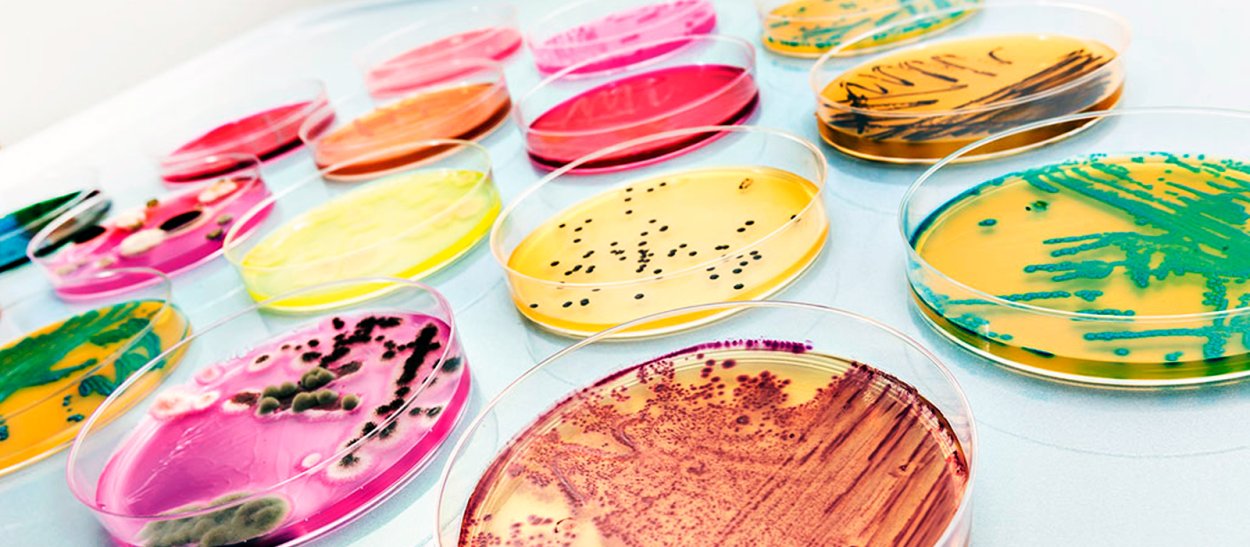
Австралийский эвкалипт
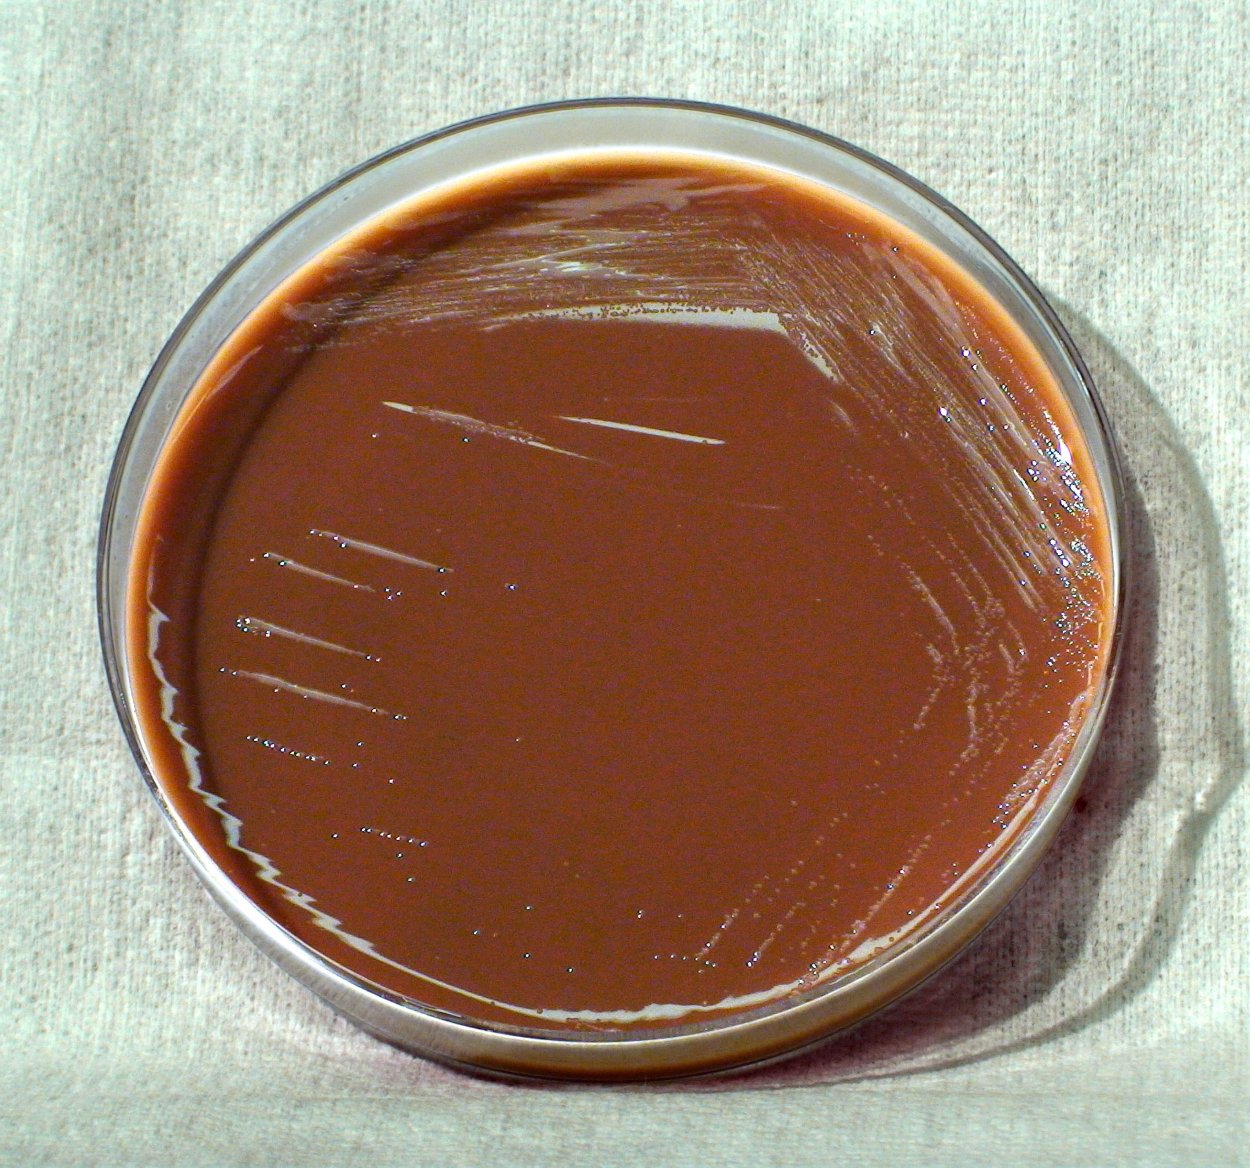
Колонии бактерий в чашке Петри

Дерево агар

Колчанное дерево

Дуб Комптон Хилл


Тайер Мартина агар


Уд агаровое дерево

Сандаловое дерево Африка

Драконовое дерево Сокотра

Реликтовая сосна в Зуре

Агар Плоскирева

Орлиное алойное дерево

Дерево Баньян в Индии

Эвкалипт розовоцветковый

Удовое дерево — аквилария.
Раскидистое дерево

Эвкалипт deglupta
Австралийский эвкалипт

Смоковница дерево

ЛИМУЗЕНСКИЙ дуб

Мускус дерево

Эвкалипт Австралия

Gaharu дерево

Красивое дерево

Дерево Утун

Одинокое дерево

Алойное дерево

Японский клен дерево

Радужный эвкалипт Гавайи

Дерево Радужный эвкалипт

Сосна Мафусаил

Агар древесина

Красивое дерево


Фикус бенгальский

Дуб дерево

Чипа фимиам Папп

Дерево Утун Геншин

Aquilaria malaccensis

Aquilaria agallocha

Aquilaria sinensis

Уд агаровое дерево

Сандаловое дерево удовое дерево

Сандаловое дерево древесина

Сосна Мафусаил. Калифорния

Таксодиум мексиканский дерево Туле

Махагониевое дерево

Удовое дерево

Удовая древесина что это

Секвойя Мафусаил

Панский дуб Белгородская область

Родовая дерево

Уд агаровое дерево

Сосна Мафусаил

Сосна остистая межгорная Калифорния

Ангельский дуб Южная Каролина

Орлиное алойное дерево

Уд агаровое дерево в парфюмерии

Чашка Петри Флеминга

Баньян: дерево Махабодхи

Эвкалипт Радужный

Эвкалипт бесстыдница

Драконовое дерево на Тенерифе

Уд агаровое дерево

Сосна остистая Мафусаил

Коричное дерево Шри-Ланка
Колонии бактерий в чашке Петри

Виргинский дуб

Aquilaria agallocha

Lactobacillus Acidophilus на чашке Петри

Сандаловое дерево на белом фоне

Лечебница Сосновый Бор

Картас дерево

Деревья